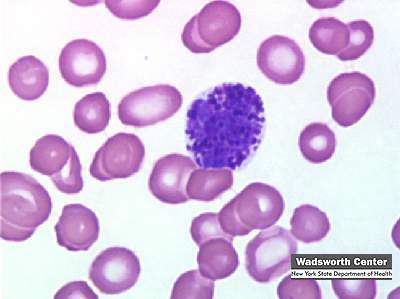
Identifying Leukocytes - ProProfs Quiz

← Katarzyna Kluk Pod białym bocianem wykluwa się lew vojtech Dan vojtech极限运动摄影欣赏 →
If you are looking for Leukocytes. Causes, symptoms, treatment Leukocytes you've visit to the right place. We have 17 Pictures about Leukocytes. Causes, symptoms, treatment Leukocytes like Leukocytes. Causes, symptoms, treatment Leukocytes, Leukocytes and also #leukocytes on Tumblr. Here you go:
Leukocytes. Causes, Symptoms, Treatment Leukocytes
 drugline.org
drugline.org
leukocytes morphology leukocyte blood medical cells histology diagram anatomy cell smear stain veterinary tissue microscopy causes definition hematology connective
WBC Normal Range? Child, Male, Female, Significance (White Blood Cell)
 dentgap.com
dentgap.com
wbc range normal blood procedure thomas cells count purpose results kim credit flickr
Leukocyte | Definition Of Leukocyte By Medical Dictionary
 medical-dictionary.thefreedictionary.com
medical-dictionary.thefreedictionary.com
leukocytes leukocyte types definition medical spm transport seven per days week
Identify The Leukocytes
 www.purposegames.com
www.purposegames.com
leukocytes purposegames
Stromal Giant, Mast, Multinucleate Plasma Cells, Neutrophils
 www.hss.edu
www.hss.edu
stromal giant cell plasma multinucleate cells stroma
Polymers | Special Issue : Antibacterial Polymers: From Natural
 www.mdpi.com
www.mdpi.com
jaw osteomyelitis polymers human lower irradiation surrounding mdpi clinical
WBC Pathology. (Subject 11) - Online Presentation
 en.ppt-online.org
en.ppt-online.org
leukocytosis ppt
#leukocytes On Tumblr
 www.tumblr.com
www.tumblr.com
hiv macrophages swarming depicts virions inflammation
Identifying Leukocytes - ProProfs Quiz
www.proprofs.com
www.proprofs.com
leukocyte leukocytes identifying basofilo basophils wbc basófilo basophil linfocitos granulocytes
My Veterinary Journal — Lymphoid Tissues
 vetplease.tumblr.com
vetplease.tumblr.com
lymphoid
Identifying Leukocytes - ProProfs Quiz
 www.proprofs.com
www.proprofs.com
segmentado neutrophil neutrofilo leukocytes leukocyte secondary hematology neutrófilo proprofs phagocytes segmented neutropenia neutrophils hematologia hematica granulocytes seg
Leukocytes And Its Types - YouTube
 www.youtube.com
www.youtube.com
Can You Identify These Three Leukocytes? | Medical Laboratories
 www.medical-labs.net
www.medical-labs.net
leukocytes medical identify three kaynak
Defense Mechanisms
 sphweb.bumc.bu.edu
sphweb.bumc.bu.edu
defenses
Leukocytes
 www.cellavision.com
www.cellavision.com
leukocytes monocyte lymphocyte
Immune Response - Your Body's First Line Of Defense.
 www.immuneresponse.org
www.immuneresponse.org
immune which system cells response defense macrophage lymphocytes consisting leucocytes blood form human line
Band Neutrophil
neutrophil band hematology imagebank
Identifying leukocytes. Leukocyte leukocytes identifying basofilo basophils wbc basófilo basophil linfocitos granulocytes. Wbc pathology. (subject 11)